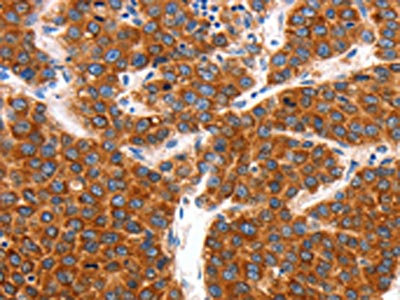

KCNC2 Antibody
-
中文名稱:KCNC2兔多克隆抗體
-
貨號:CSB-PA945687
-
規格:¥1100
-
圖片:
-
The image on the left is immunohistochemistry of paraffin-embedded Human liver cancer tissue using CSB-PA945687(KCNC2 Antibody) at dilution 1/100, on the right is treated with synthetic peptide. (Original magnification: ×200)
-
The image on the left is immunohistochemistry of paraffin-embedded Human colon cancer tissue using CSB-PA945687(KCNC2 Antibody) at dilution 1/100, on the right is treated with synthetic peptide. (Original magnification: ×200)
-
-
其他:
產品詳情
-
Uniprot No.:
-
基因名:KCNC2
-
別名:KCNC2; Potassium voltage-gated channel subfamily C member 2; Shaw-like potassium channel; Voltage-gated potassium channel Kv3.2
-
宿主:Rabbit
-
反應種屬:Human,Mouse,Rat
-
免疫原:Synthetic peptide of Human KCNC2
-
免疫原種屬:Homo sapiens (Human)
-
標記方式:Non-conjugated
-
抗體亞型:IgG
-
純化方式:Antigen affinity purification
-
濃度:It differs from different batches. Please contact us to confirm it.
-
保存緩沖液:-20°C, pH7.4 PBS, 0.05% NaN3, 40% Glycerol
-
產品提供形式:Liquid
-
應用范圍:ELISA,IHC
-
推薦稀釋比:
Application Recommended Dilution ELISA 1:1000-1:2000 IHC 1:150-1:500 -
Protocols:
-
儲存條件:Upon receipt, store at -20°C or -80°C. Avoid repeated freeze.
-
貨期:Basically, we can dispatch the products out in 1-3 working days after receiving your orders. Delivery time maybe differs from different purchasing way or location, please kindly consult your local distributors for specific delivery time.
-
用途:For Research Use Only. Not for use in diagnostic or therapeutic procedures.
相關產品
靶點詳情
-
功能:Voltage-gated potassium channel that mediates transmembrane potassium transport in excitable membranes, primarily in the brain. Contributes to the regulation of the fast action potential repolarization and in sustained high-frequency firing in neurons of the central nervous system. Homotetramer channels mediate delayed-rectifier voltage-dependent potassium currents that activate rapidly at high-threshold voltages and inactivate slowly. Forms tetrameric channels through which potassium ions pass in accordance with their electrochemical gradient. The channel alternates between opened and closed conformations in response to the voltage difference across the membrane. Can form functional homotetrameric and heterotetrameric channels that contain variable proportions of KCNC1, and possibly other family members as well; channel properties depend on the type of alpha subunits that are part of the channel. Channel properties may be modulated either by the association with ancillary subunits, such as KCNE1, KCNE2 or KCNE3 or indirectly by nitric oxide (NO) through a cGMP- and PKG-mediated signaling cascade, slowing channel activation and deactivation of delayed rectifier potassium channels. Contributes to fire sustained trains of very brief action potentials at high frequency in retinal ganglion cells, thalamocortical and suprachiasmatic nucleus (SCN) neurons and in hippocampal and neocortical interneurons. Sustained maximal action potential firing frequency in inhibitory hippocampal interneurons is negatively modulated by histamine H2 receptor activation in a cAMP- and protein kinase (PKA) phosphorylation-dependent manner. Plays a role in maintaining the fidelity of synaptic transmission in neocortical GABAergic interneurons by generating action potential (AP) repolarization at nerve terminals, thus reducing spike-evoked calcium influx and GABA neurotransmitter release. Required for long-range synchronization of gamma oscillations over distance in the neocortex. Contributes to the modulation of the circadian rhythm of spontaneous action potential firing in suprachiasmatic nucleus (SCN) neurons in a light-dependent manner.
-
基因功能參考文獻:
- these data suggest that reduction of KCNC2 is associated with modified hepatic gluconeogenesis and increased ER stress on obesity-mediated diabetic risk. PMID: 27623749
- Kv3.2 is not different in distribution or in level between normal and schizophrenia cases, nor influenced by antipsychotic drugs, in any brain region tested PMID: 23628987
- This family's complex phenotype is associated with a new chromosomal deletion, which suggests potential roles for the two genes, KCNC2 and ATXN7L3B, in human neurological disease. PMID: 23475819
- Although all KV3 subunit transcripts are significantly expressed at embryonic age in whole brain extracts, only KV3.1, KV3.2 and KV3.4 subunit transgenic proteins are present. PMID: 21912965
-
相關疾病:A chromosomal aberration involving KCNC2 has been found in a mother and her two children with varying degrees of neurodevelopmental delay and cerebellar ataxia. One child also exhibits episodes of unresponsiveness suggestive of absence seizures and facial dysmorphism. Deletion at 12q21.1 deletes exons 3-5 of KCNC2.
-
亞細胞定位:Cell membrane; Multi-pass membrane protein. Membrane; Multi-pass membrane protein. Perikaryon. Cell projection, axon. Cell projection, dendrite. Cell junction, synapse, postsynaptic cell membrane. Cell junction, synapse, presynaptic cell membrane. Cell junction, synapse, synaptosome. Cell junction, synapse. Apical cell membrane. Basolateral cell membrane.
-
蛋白家族:Potassium channel family, C (Shaw) (TC 1.A.1.2) subfamily, Kv3.2/KCNC2 sub-subfamily
-
數據庫鏈接:
Most popular with customers
-
-
Phospho-YAP1 (S127) Recombinant Monoclonal Antibody
Applications: ELISA, WB, IHC
Species Reactivity: Human
-
-
-
-
-
-